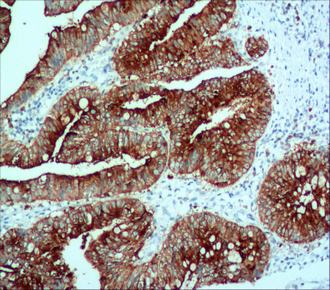
产品封面图

相关产品推荐更多 >
万千商家帮你免费找货
0 人在求购买到急需产品
- 详细信息
- 询价记录
- 文献和实验
- 技术资料
- 库存:
99
- 保质期:
已收到实际货物为准
- 供应商:
北京诺博莱德科技有限公司
- 保存条件:
已收到实际货物为准
详细信息:
| 适用组织: | 石蜡切片 |
| 阳性部位: | 质 |
| 阳性对照: | 结肠癌 |
| 特异性 : | 此抗体与人的CEA反应,其它种属未检测。 |
| 推荐效价: | •原液使用前应以适当比例稀释 推荐稀释度为1:100~1:200 •工作液不必稀释,直接滴加使用 |
风险提示:丁香通仅作为第三方平台,为商家信息发布提供平台空间。用户咨询产品时请注意保护个人信息及财产安全,合理判断,谨慎选购商品,商家和用户对交易行为负责。对于医疗器械类产品,请先查证核实企业经营资质和医疗器械产品注册证情况。
- 作者
- 内容
- 询问日期
文献和实验. A rabbit polyclonal antisera is also available (101c500; BAbCO) but in our hands this was less reactive. The antibody cleanup protocol is now a seperate document Protocol Cells are grown in 5 mls of YPAD to an O.D. 600 of 0.75 to 1.
suspended in PBS. A rabbit polyclonal antisera is also available (101c500; BAbCO) but in our hands this was less reactive. The antibody cleanup protocol is now a seperate document Protocol Cells are grown in 5 mls of YPAD to an O.D. 600
祝贺〖雅裕睿安〗成为Signalway Antibody(SAB)独家
货号T501,产品描述:HA-Tag Rabbit Polyclonal Antibody;规格 50 ul / 100 ul; 货号T503,产品描述:Anti-DYKDDDDK Polyclonal Antibody;规格 50 ul / 100 ul; 货号T504,产品描述:Myc-Tag Mouse Monoclonal Antibody;规格 50 ul / 100 ul; 货号
技术资料暂无技术资料 索取技术资料